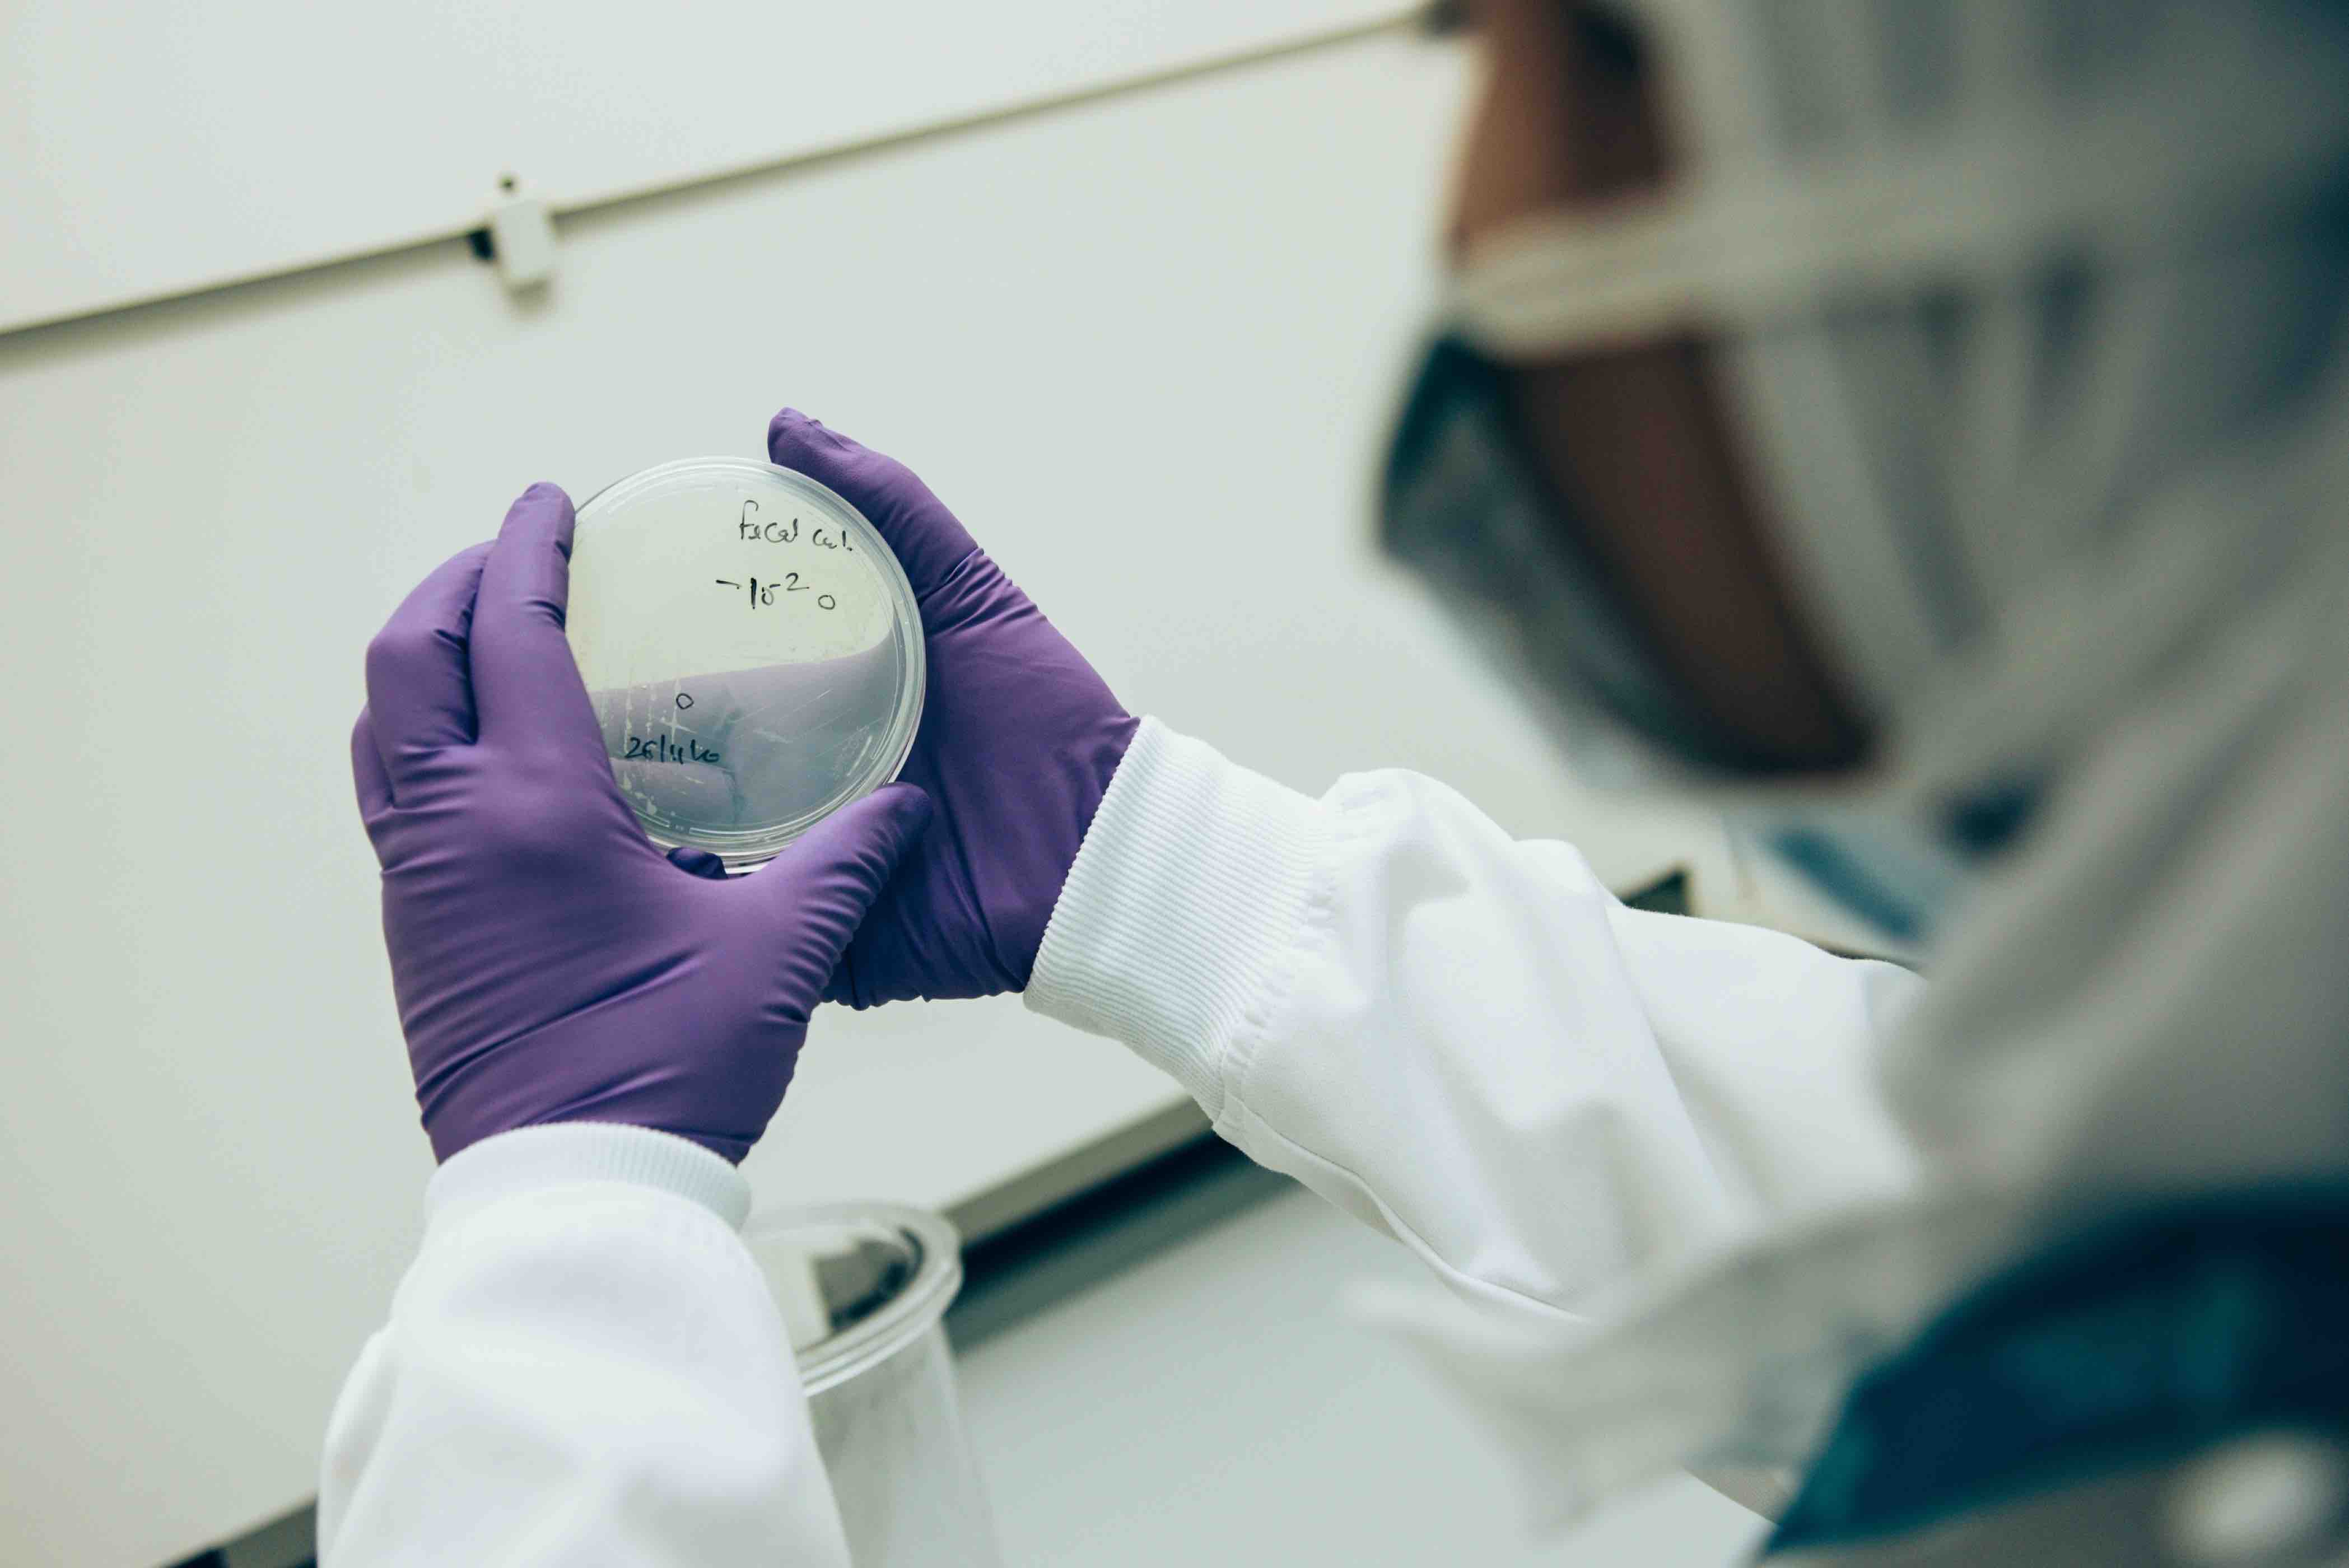
How our saliva is a stepping stone to precision medicine - QF - 02

For the latest COVID-19 information and updates from Qatar Foundation, please visit our Statements page
Dr. Souhaila Al Khodor, Director of Sidra Medicine’s Maternal and Child Health Program, has developed the first salivary microbiome composition of the Qatari population
What our saliva does for us is not always appreciated. As well as helping us digest our food, saliva carries information about the physiological state of the body. And that means real-time monitoring of salivary data can provide useful translational clinical applications for detecting various diseases.
Saliva acts as a mirror for the body's health
The shift toward personalized, or precision, medicine can be propelled by advances in diagnostic tools. One of these is saliva diagnostics. Utilizing saliva to identify and measure biomarkers has the potential to enable highly individualized diagnosis, prognosis and treatment.
Souhaila Al Khodor
“Saliva acts as a mirror for the body's health,” says Dr. Souhaila Al Khodor, Director of the Maternal and Child Health Program in the Research Department at Qatar Foundation (QF) member Sidra Medicine - a women’s and children’s hospital that has precision medicine built into its core pillars of patient care, research and medical education.
“It is composed of RNA, DNA, proteins, electrolytes, metabolites, and microbiota. Variation in either of these components can indicate a change in the health of an individual.
“The salivary microbiome not only differs from disease to disease, but it also changes based on ethnicity. This is partly due to differences in genetics, diet and environmental factors.”
If data representing Arabs is missing, the first responsibility to fill that gap lies with us as Arab scientists
The degree of variation in the salivary biome at a population level has not been studied extensively, and the few studies that do exist do not take into account the Arab population or Qatari population.
Now Dr. Al Khodor’s group has successfully reported the first-ever salivary microbiome composition in the Qatari population, using data from 1,000 individuals participating in the Qatar Genome Programme (QGP).
“If data representing Arabs is missing, the first responsibility to fill that gap lies with us as Arab scientists. We hope this first-ever characterization of the Qatari salivary microbiome will pave the way for future salivary diagnostic studies.”
To advance the field of saliva diagnostics, it is vital to create a comprehensive database of biomarkers that signal the presence of a disorder in saliva. Once fully catalogued, changes in biomarker levels can play a key role in maintaining well-being and early detection of diseases.
“The success of salivary diagnostics depends on the identification of clinically validated biomarkers that can be reliably linked to a specific disease and provide reliable targets for therapy,” said Dr. Al Khodor.
In an ongoing project funded by QF’s Qatar National Research Fund, Dr Al Khodor is researching whether changes in the salivary microbiome and proteome can predict diabetes and cardiovascular disease (CVD), among others.
“The oral cavity is host to many microbes, and the question I am trying to answer is: can I, by analyzing the biomarkers in a saliva sample know whether a patient is diabetic or is prone to CVD?” said Dr. Al Khodor.
In the future, salivary tests may pave the way for chair-side diagnosis of multiple diseases, allowing real-time health monitoring, leading to personalized preventative medicine
Another aspect of Dr. Al Khodor’s research aims to address is how specific microbes contribute towards an individual developing a disease. For example: how is a particular bacterium putting a person at a high risk of CVD? Is it causing more fat assimilation? Is it contributing to an increase in blood pressure?
Bodily fluids like blood and urine have been used in diagnostics for decades, but there are reasons why scientists are now turning to saliva as well. “Saliva is one of the most ideal diagnostic tools,” says Dr. Al Khodor. “It is inexpensive, noninvasive, and easy to handle. More importantly, minimal patient discomfort makes it a favorable choice over other bodily fluids.
“The ongoing pandemic has really highlighted the important role salivary diagnostics can play and, more importantly, the minimal patient discomfort they cause. If you ask someone whether they would like to spit in a tube or have a swab scratch their upper nasal track, it would not be an exaggeration to say nearly 100 percent would choose the former”.
Given their speed and cost effectiveness, salivary-based diagnostic techniques can potentially allow screening of an entire population for a specific disease in a timely fashion.
“Validated salivary biomarkers combined with powerful detection tools have the potential to open a new innovative frontier in personalized healthcare,” said Dr. Al Khodor.
“In the future, salivary tests may pave the way for chair-side diagnosis of multiple diseases, allowing real-time health monitoring, leading to personalized preventative medicine.”